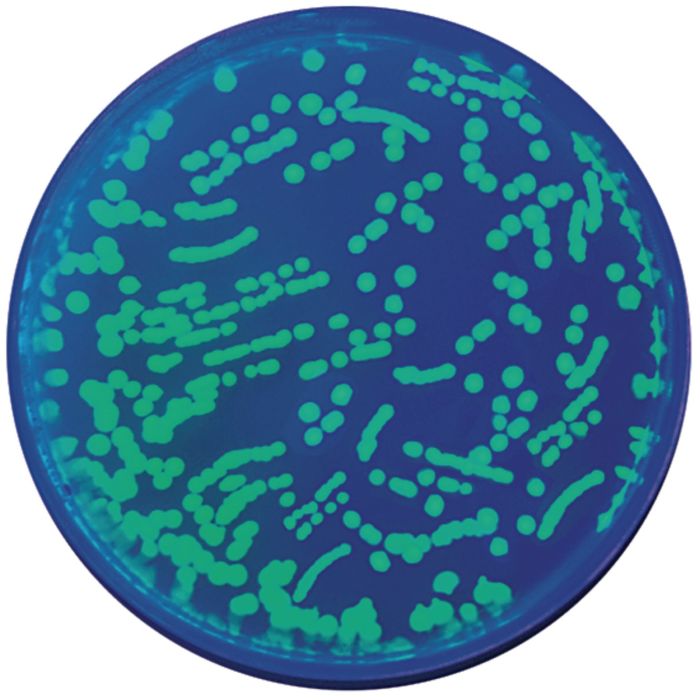

The home of Specialist Crafts
Checkout using your account
This form is protected by reCAPTCHA - the Google Privacy Policy and Terms of Service apply.
Checkout as a new customer
Creating an account has many benefits:
In this experiment, students will explore the biological process of bacterial transformation using E. coli and plasmid DNA.
At the end of the activity, students will have experience observing and analyzing acquired traits (ampicillin resistance and fluorescence) as exhibited by transformed bacterial cells.
| Web Price | AED 1,321.95 |
|---|---|
| Web Code | FELHC1482336 |
| Alternative Codes | FELHC1482336, HC1482336 |
| Pack Size | Each |